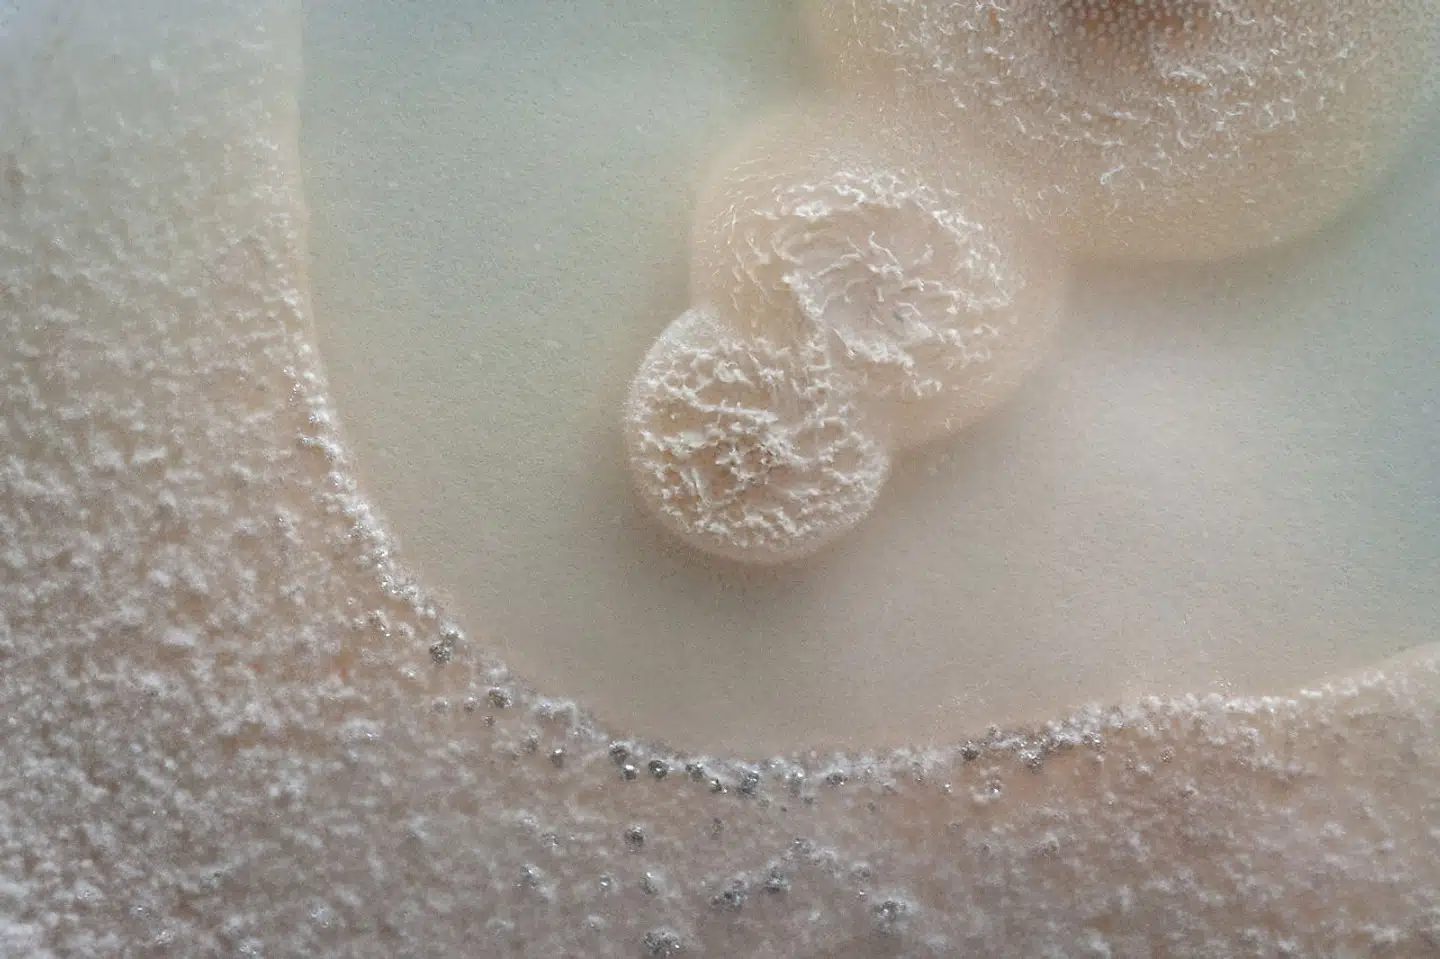

24 spørgsmål til professoren. De er vitale for vores klode og vores kroppe. Mykolog Lene Lange fortæller om svampene, der kan redde en udfordret verden.
Svampenes hemmelige liv
Svampe er langt mere end paddehatte i flødesauce.
Millioner af mikroskopiske arter udgør krumtappen i klodens stofkredsløb, og selv er vi afhængige af svampe, der gror på hud og slimhinder.
Svampe er verdensmestre i enzymproduktion, fortæller mykolog Lene Lange, og derfor kan de redde en udfordret verden.
Udsendelsen er sponsoreret af Carlsbergfondet.
Del:

